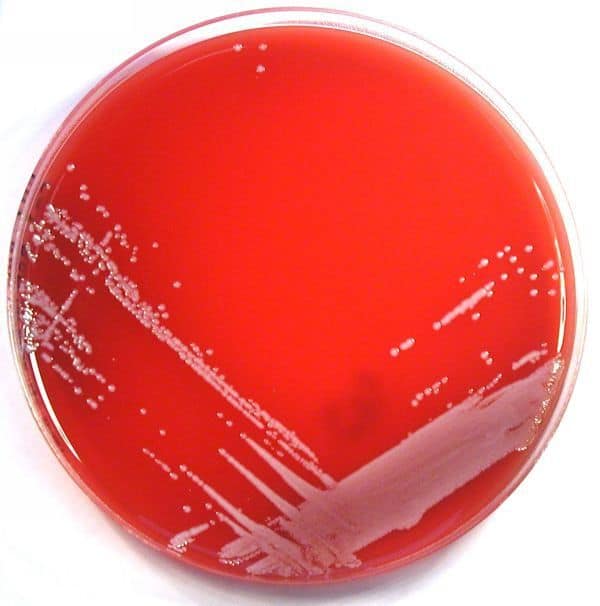

Medios de cultivo para alimentos y bebidas
-
Disponibilidad de Medios de cultivo para alimentos y bebidas:En stock
-
Tiempo de entrega de Medios de cultivo para alimentos y bebidas:Excelentes tiempos de entrega
Descripción de Medios de cultivo para alimentos y bebidas:
En Serco Comercial ofrecemos gran variedad de Medios de cultivo para alimentos y bebidas. Tenemos productos para la identificación de gran número de patógenos, desde E. coli hasta Listeria. Nuestros Medios de Cultivo CHROMagar son cromogénicos, por lo que ayudan a la identificación de las cepas, son fáciles de usar, reducen el tiempo de pruebas, son confiables, se pueden trasladar al sitio de muestreo y su desecho es sencillo. Contáctanos aquí para mayor información.
En Serco Comercial ofrecemos gran variedad de Medios de cultivo para alimentos y bebidas. Tenemos productos para la identificación de gran número de patógenos, desde E. coli hasta Listeria. Nuestros Medios de Cultivo CHROMagar son cromogénicos, por lo que ayudan a la identificación de las cepas, son fáciles de usar, reducen el tiempo de pruebas, son confiables, se pueden trasladar al sitio de muestreo y su desecho es sencillo. Contáctanos aquí para mayor información.


-
Cobertura de Medios de cultivo para alimentos y bebidas Nacional
4.8
Gabriela Ramirez Jimenez
4 años atrás
robert chavolla
8 años atrás
ale kim
8 años atrás
GABRIEL MENDOZA
7 años atrás
¡Atención! Las opiniones expuestas se toman de las que los usuarios escribieron en el registro de Google de esta empresa. No son directamente de nuestra plataforma en Cosmos. Te sugerimos validar tú mismo esta información.
Aplicaciones de Medios de cultivo para alimentos y bebidas
Los productos que ofrecemos pueden ser utilizados en la industria alimentaria, de las bebidas, farmacéutica, bacteriología clínica, microbiología industrial, pruebas de agua y monitoreo ambiental.
Uso industrial de Medios de cultivo para alimentos y bebidas
Nuestros medios de cultivo se utilizan para analizar la presencia o ausencia de E-coli en agua y alimentos, coliformes, Yersinia, Salmonella, Estafilococo Aureus, Listeria Monocytogenes, Vibrio Parahaemolyticus, Vibrio Vulnificus, Pseudomonas, entre otras.


-
Cobertura de Medios de cultivo para alimentos y bebidas Nacional
4.8
Gabriela Ramirez Jimenez
4 años atrás
robert chavolla
8 años atrás
ale kim
8 años atrás
GABRIEL MENDOZA
7 años atrás
¡Atención! Las opiniones expuestas se toman de las que los usuarios escribieron en el registro de Google de esta empresa. No son directamente de nuestra plataforma en Cosmos. Te sugerimos validar tú mismo esta información.
Otros productos que vende Serco Comercial

$ 22,700 MXN
Min. Caja con 100




$ 22,700 MXN
Min. Caja con 100



¿Necesitas una cotización personalizada?
Nuestro equipo técnico puede ayudarte a seleccionar Medios de cultivo para alimentos y bebidas ideal según tu línea de producción, velocidad y tipo de material.